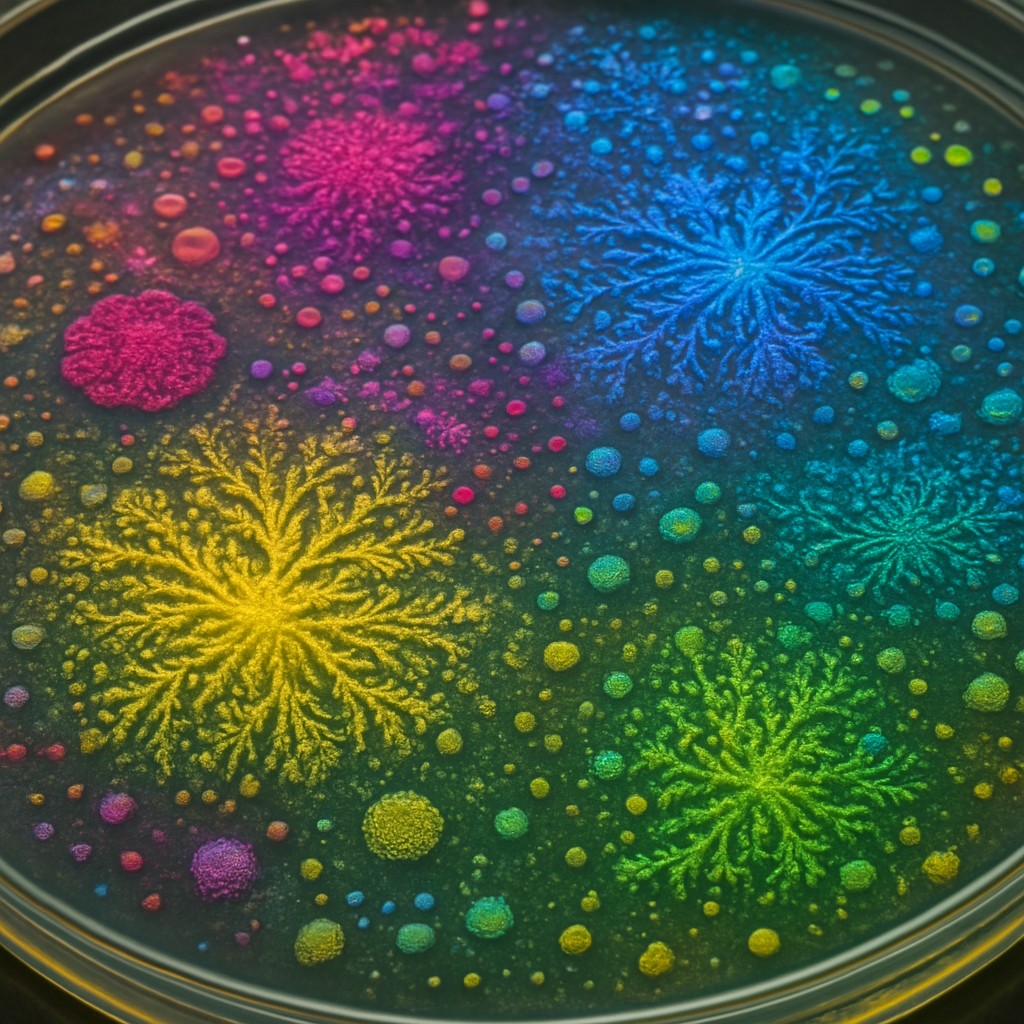

Created by
wide landscape with natural scenery
Style Used
Bacteriological Agar Artby @stylecreator
This style recreates images using bacterial cultures growing on agar plates. Different bacterial strains create various colors and textures, turning petri dishes into living canvases that evolve over time.